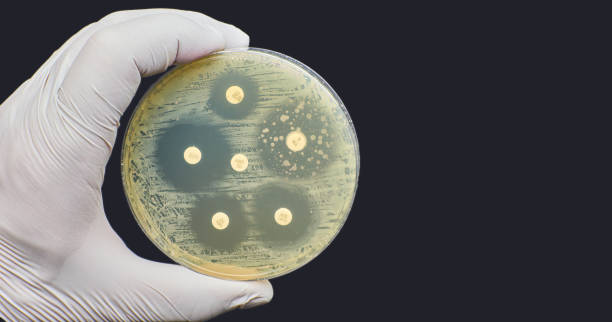

Con un alto sentido de la responsabilidad social, Productos Abadi, destacada empresa dentro del sector alimentario mexicano, se muestra a favor de todas aquellas acciones y medidas que contribuyan a garantizar la seguridad alimentaria de la población.
La Organización Mundial de la Salud (OMS) advierte que la resistencia bacteriana a los antibióticos representa actualmente una de las mayores amenazas para la salud mundial, la seguridad alimentaria y el desarrollo.
Aunque se trata de un fenómeno natural, el uso indebido y excesivo de antibióticos en humanos, animales y sistemas productivos acelera su aparición y propagación.
Esta situación no solo compromete la eficacia de los tratamientos médicos, sino que también tiene efectos directos en la producción y la inocuidad de los alimentos.
¿Qué riesgos representa y cómo impacta en el sistema alimentario? Aquí profundizamos más al respecto.
Productos Abadi – ¿Qué es la resistencia bacteriana y cuáles son sus riesgos?
De acuerdo con la Comisión de la Unión Europea (UE), la resistencia bacteriana es la capacidad de bacterias y hongos para neutralizar los efectos de los antibióticos o biocidas diseñados para eliminarlos o controlarlos.
Se habla de resistencia múltiple o multirresistencia cuando una cepa bacteriana presenta resistencia a varios antimicrobianos distintos. Como resultado, los microorganismos no son eliminados y continúan multiplicándose.
Este fenómeno conlleva riesgos significativos para la salud pública y puede afectar a cualquier persona, sin distinción de edad o nacionalidad. Entre las principales consecuencias se encuentran:
- El aumento del número de infecciones difíciles de tratar, como neumonía, tuberculosis, gonorrea y salmonelosis.
- La prolongación de las estancias hospitalarias.
- El incremento de los costos asociados a la atención médica.
- El aumento de la mortalidad debido a infecciones resistentes.
¿Cómo afecta la resistencia bacteriana a la producción de alimentos?
La inocuidad alimentaria, de acuerdo con la FAO, es la disciplina, proceso o acción científica destinada a prevenir que los alimentos contengan sustancias que puedan dañar la salud humana. Ésta puede verse seriamente comprometida por la resistencia bacteriana.
Con amplia experiencia dentro del sector, Productos Abadi implementa medidas apegadas a la norma internacional ISO 22000. Ésta especifica los requisitos de un sistema de gestión de la inocuidad de los alimentos (SGIA). Además, garantiza que las organizaciones de la cadena alimentaria puedan brindar productos y servicios seguros.
Cuando la inocuidad alimentaria se ve comprometida, los microorganismos resistentes llegan a los alimentos con mayor facilidad, frecuencia y por distintas vías, entre las que destacan:
- Durante el sacrificio y procesamiento de animales. Las bacterias pueden contaminar la carne y sus derivados a través de equipos, herramientas o recipientes de procesamiento y almacenamiento contaminados.
- A través del entorno. Los microorganismos resistentes presentes en el excremento animal pueden dispersarse en el ambiente que los rodea.
- En la producción agrícola. Frutas y verduras pueden contaminarse por el contacto con tierra, agua o fertilizantes contaminados con heces de animales.
Estas vías de contaminación pueden generar consecuencias negativas tanto para la salud de los consumidores como para el rendimiento y la sostenibilidad de los productores, al aumentar los riesgos sanitarios, las pérdidas económicas y las restricciones comerciales.
Sin duda, se trata de un desafío complejo que trasciende el ámbito de la salud humana y tiene un impacto directo en la producción y la inocuidad de los alimentos. Su avance compromete la seguridad alimentaria, eleva los riesgos para los consumidores y afecta la viabilidad de los sistemas productivos.
Por ello, resulta indispensable implementar medidas que permitan prevenir y controlar la propagación de la resistencia bacteriana en los sistemas de producción de alimentos.
Frente a este escenario, Productos Abadi reconoce como fundamental la promoción del uso responsable de antibióticos y el fortalecimiento de las prácticas de higiene, control y prevención a lo largo de toda la cadena alimentaria, con el fin de proteger la salud pública y garantizar alimentos seguros.

